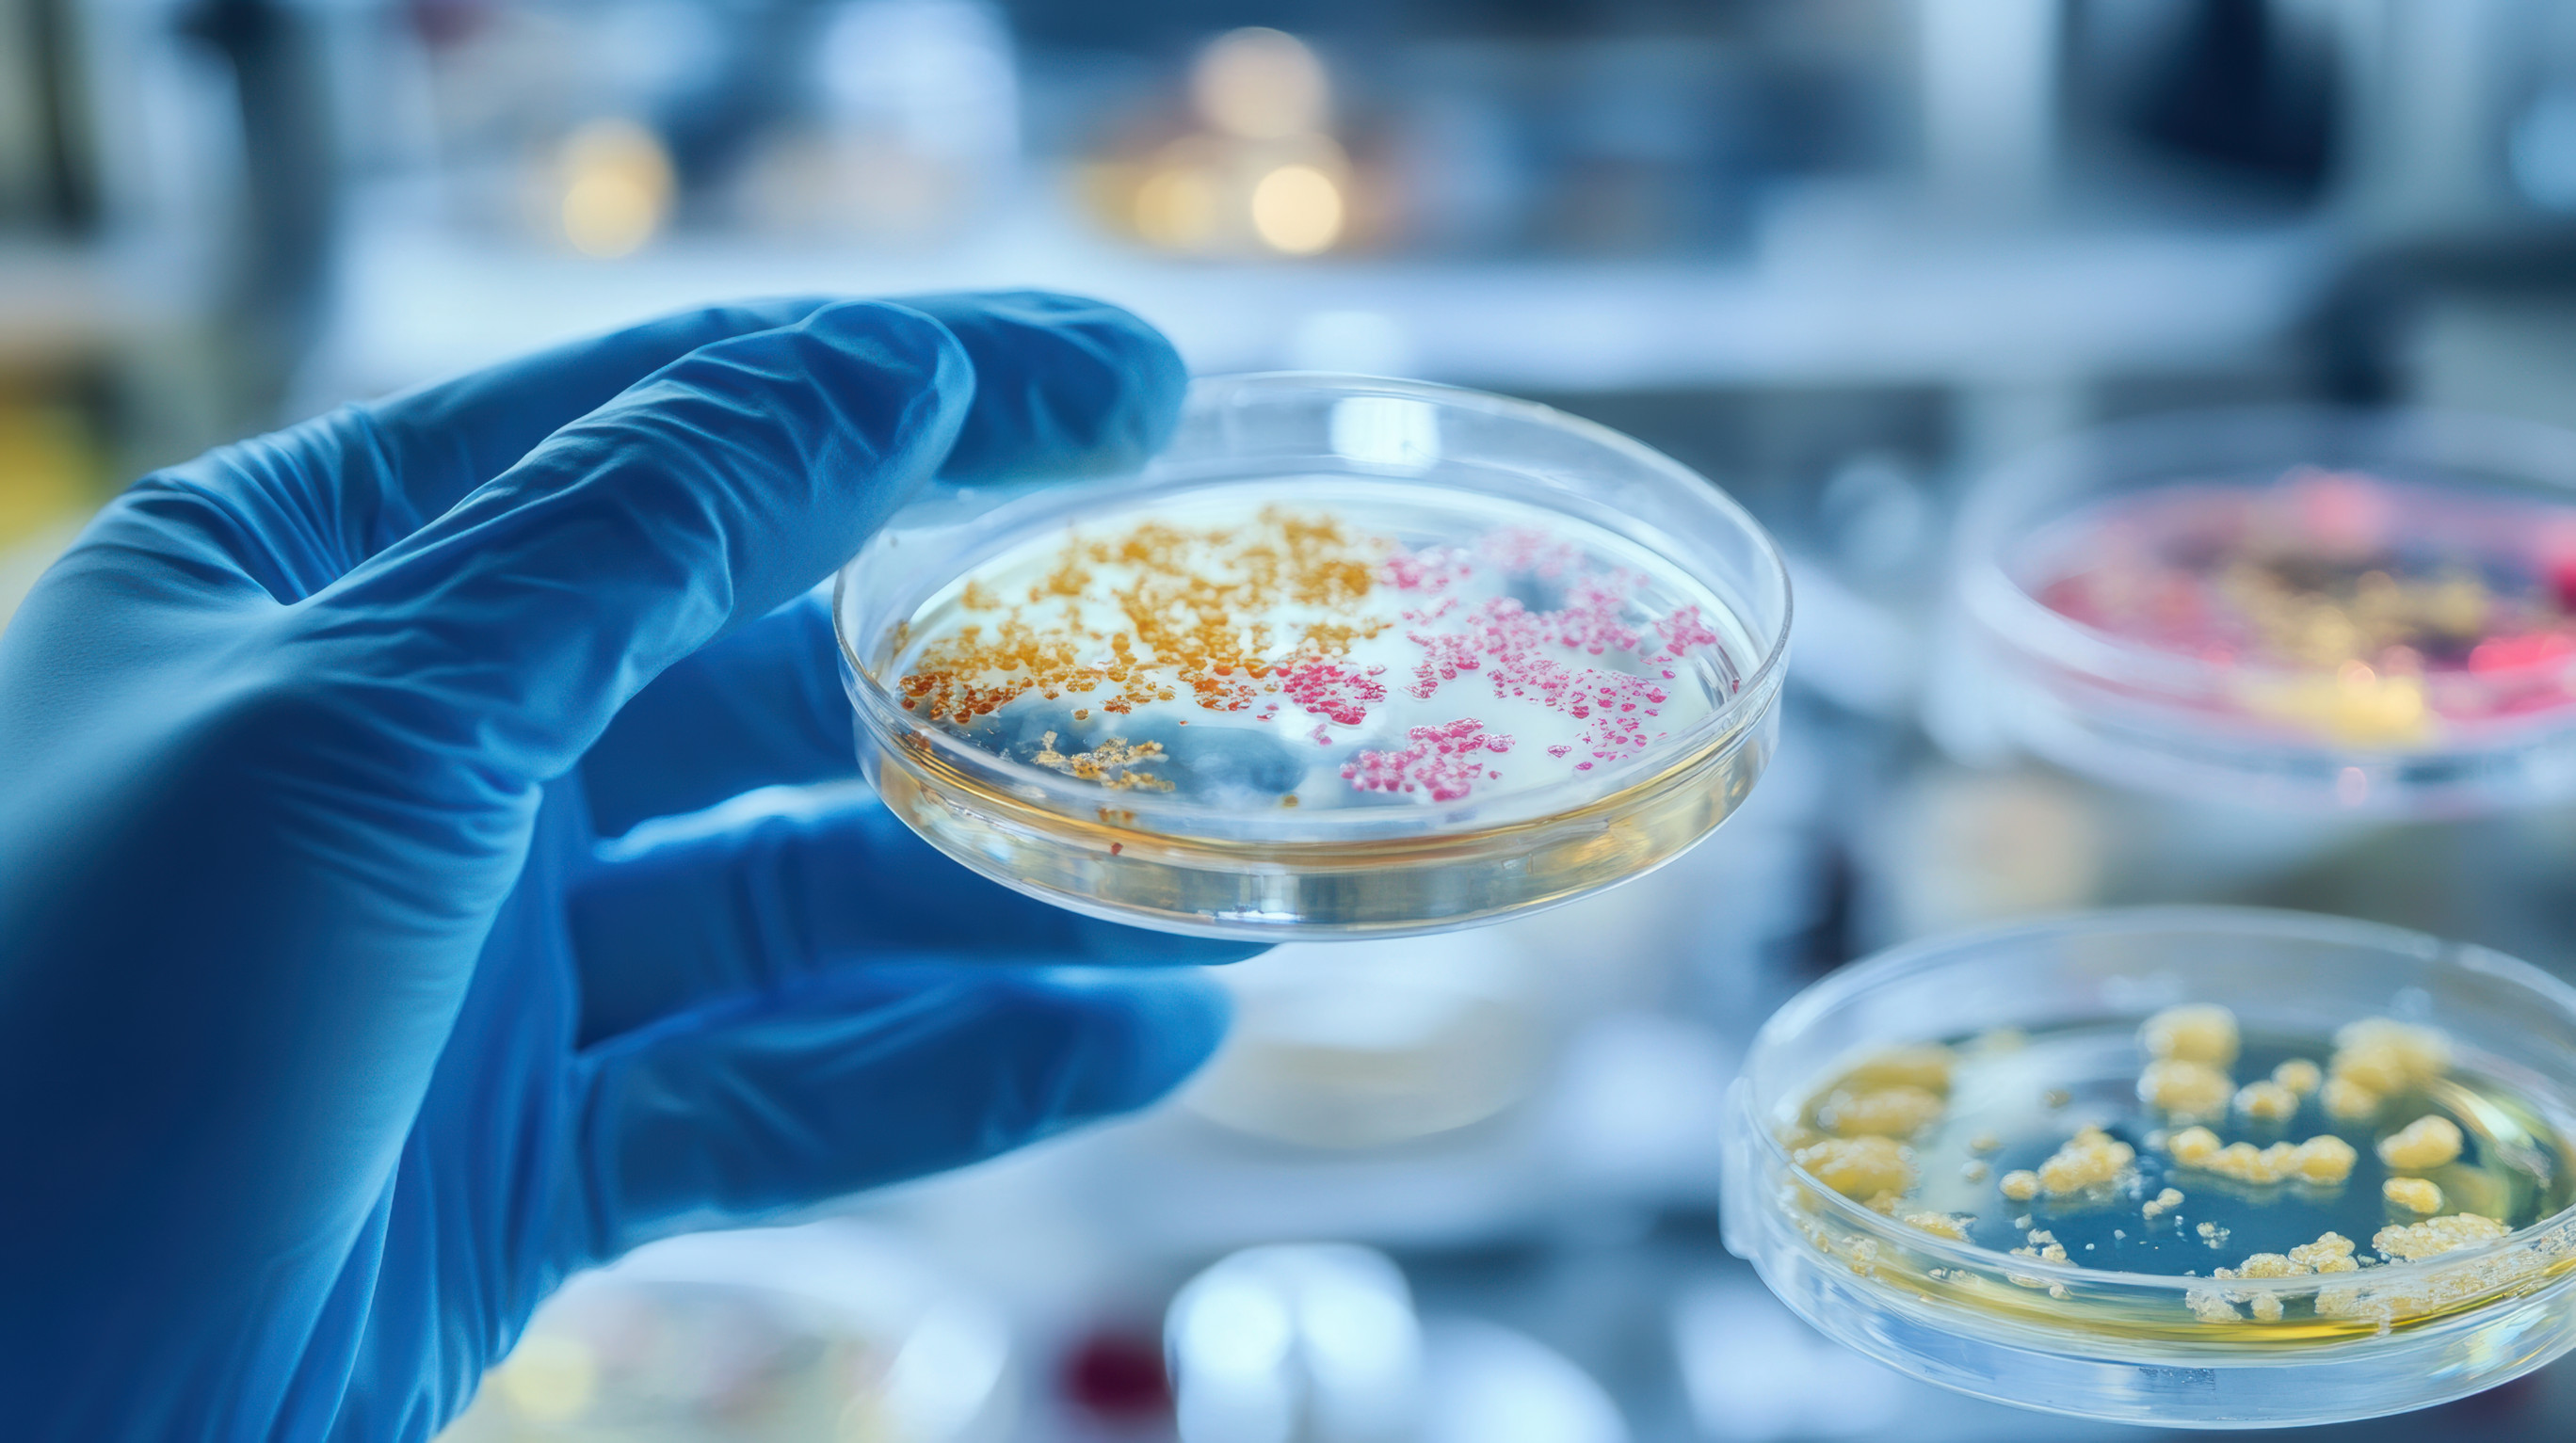
Mikrobiom i dieta zachodnia – poznano mechanizm zwiększający rozwój raka jelita grubego

34. finał Wielkiej Orkiestry Świątecznej Pomocy zbliża się wielkimi krokami. Już w tę niedzielę w tysiącach miejscowości rozsianych po całym kraju wolontariusze będą zbierać środki, tym razem pod hasłem "Zdrowe brzuszki naszych dzieci". Nie inaczej będzie w gminie Ceków-Kolonia.
"Chciałabym serdecznie zaprosić wszystkich mieszkańców gminy Ceków-Kolonia i przyjaciół naszej gminy na finał Wielkiej Orkiestry Świątecznej Pomocy do Cekowa. Od 7 lat przy bibliotece działa nasz sztab i od 7 lat łączymy się, dzielimy dobrem i pomagamy w szczytnych celach. W tym roku zbieramy na diagnostykę i leczenie chorób przewodu pokarmowego u dzieci. W tę niedzielę od rana nasi wolontariusze, którzy są sercem całej naszej akcji, będą kwestować w naszych miejscowościach, a także zapukają do naszych domów. To właśnie dzięki ich energiii zaangażowaniu finał nasz ma prawdziwą moc" - powiedziała radiuCENTRUM Laura Wojtysiak, dyrektorka Gminnej Biblioteki Publicznej im. Stefana Floriana Garczyńskiego w Cekowie-Kolonii.

na fot.: Laura Wojtysiak / dyrektorka Gminnej Biblioteki Publicznej im. Stefana Floriana Garczyńskiego w Cekowie-Kolonii
Cekowski finał w sali OSP w Cekowie rozpocznie się o 15:30, w programie licytacje, morsowanie, próba bicia rekordu w grupowym tańcu poloneza, występy artystyczne czy kulinarne atrakcje, o które zadbały m.in. panie z KGW. Światełko do nieba zaplanowano na 20:00.

Autor: